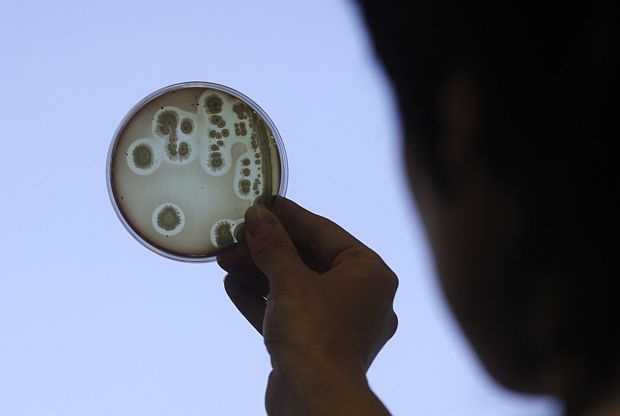

К итайски гражданин и бивш постдокторант в Университета на Индиана се е признал за виновен в това, че тайно е внесъл бактерии в Съединените щати, като ги е скрил в пратка, фалшиво декларирана като дамско бельо, съобщиха федерални прокурори, цитирани от Newsweek.
32-годишният Юхуан Сян е признал, че проби от ДНК на бактерията ешерихия коли са били укрити в пакет, изпратен от Китай до неговия адрес в Блумингтън, щата Индиана, през март 2024 г., се посочва в прессъобщение на Министерството на правосъдието на САЩ (DOJ), публикувано в петък.
В товарителницата съдържанието е било невярно описано като "бельо от изкуствени влакна", като според разследващите това е било направено с цел да се избегне митнически контрол в САЩ.
Chinese researcher at Indiana University pleads guilty to smuggling biological materials https://t.co/nNJhaAPKyH
— John Solomon (@jsolomonReports) April 14, 2026
Федералните власти съобщиха, че Сян е получил материалите от китайска компания, специализирана в научни изследвания, докато е работил като постдокторант в катедрата по биология на Университета на Индиана с J-1 изследователска виза. Федералното бюро за разследване (FBI) започва проверка, след като са засечени подозрителни пратки от Китай към лица, свързани с университета, в края на 2025 г.
"Разследващите установиха, че е необичайно Сян да закупува и изпраща дамско бельо от Китай, особено от компания, фокусирана върху научни и технологични иновации", се казва в прессъобщението на DOJ.
Сян е бил задържан и разпитан от служители на Митническата и гранична защита на САЩ на международното летище "О’Хеър" в Чикаго на 23 ноември 2025 г., след завръщането си от научна мисия във Великобритания. Прокуратурата посочва, че първоначално той е отрекъл обвиненията, но по-късно е признал, че митническата декларация умишлено е била неверна и че проби от ДНК на ешерихия коли са били скрити, за да се заобиколят американските закони.
- Какво е ешерихия коли?
Бактерията ешерихия коли може да представлява сериозен здравен риск, включително в някои случаи да доведе до смърт. Федералните власти подчертават, че съществуват строги правила за внос, за да се предотврати влизането на потенциално опасни биологични материали без надлежно разрешение.
Повечето щамове на ешерихия коли са безвредни и са част от нормалната чревна флора, като подпомагат храносмилането и производството на витамини. Някои обаче могат да причинят сериозни заболявания, включително хранително отравяне, инфекции на пикочните пътища и в тежки случаи бъбречна недостатъчност. Опасните щамове обикновено се разпространяват чрез замърсена храна или вода, включително недостатъчно термично обработено месо, сурови продукти или непастьоризирано мляко.
В научните изследвания ешерихия коли се използва широко в лабораториите, тъй като се размножава бързо и е лесна за генетични модификации. Учените често работят с ДНК на ешерихия коли или плазмиди, малки генетични фрагменти, в изследвания в областта на генетиката, земеделието и медицината. Въпреки това американското законодателство изисква биологичните материали да бъдат правилно декларирани и разрешени при внос, тъй като определени щамове или генетичен материал могат да представляват риск за общественото здраве, селското стопанство или околната среда при неправилно боравене.
Не е уточнено какъв точно щам на ешерихия коли е бил внесен.
JUST IN: Chinese national sentenced to prison for smuggling E. coli plasmid DNA from China into the U.S., concealed in women’s underwear; also admitted lying about Chinese Communist Party ties — DOJ pic.twitter.com/An8KVLckAK
— Resist Wire (@ResistWire) April 14, 2026
Съгласно споразумение за признаване на вина в Окръжния съд на САЩ за Южния окръг на Индиана, Сян е признал вина по едно обвинение за контрабанда. Той е осъден на повече от четири месеца затвор, глоба от 500 долара и една година условно освобождаване под надзор. Съдът е одобрил и разпореждане за депортиране, което предвижда незабавното му извеждане от САЩ след изтърпяване на наказанието.
По време на съдебното заседание на 7 април прокурорите са заявили, че разследващите са открили доказателства за членство на Сян в Китайската комунистическа партия и че той е излъгал за това пред имиграционните власти на САЩ. Федералните служители са посочили, че тези обстоятелства утежняват случая.
"Тези, които се опитват тайно да внесат биологични материали в Съединените щати, поемат сериозен риск за обществената безопасност", заяви специалният агент на ФБР в Индианаполис Тимъти Дж. О’Мали. "Скриването на ешерихия коли, за да се избегне откриване, показва явно пренебрежение към закона и безопасността на другите."
Разследването е включвало ФБР, Митническата и гранична защита на САЩ и други федерални агенции, отговорни за контрола и регулирането на вноса на биологични материали.

























